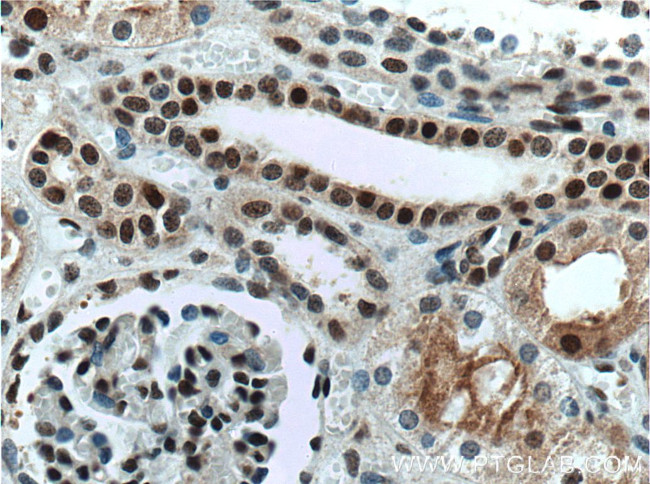
NHEJ1 Antibody in Immunohistochemistry (Paraffin) (IHC (P))
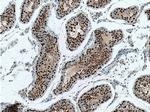
NHEJ1 Antibody in Immunohistochemistry (Paraffin) (IHC (P))

Search
Proteintech
NHEJ1 Monoclonal Antibody (1F8C7)
{{$productOrderCtrl.translations['antibody.pdp.commerceCard.promotion.promotions']}}
{{$productOrderCtrl.translations['antibody.pdp.commerceCard.promotion.viewpromo']}}
{{$productOrderCtrl.translations['antibody.pdp.commerceCard.promotion.promocode']}}: {{promo.promoCode}} {{promo.promoTitle}} {{promo.promoDescription}}. {{$productOrderCtrl.translations['antibody.pdp.commerceCard.promotion.learnmore']}}
产品信息
66552-1-IG
种属反应
宿主/亚型
分类
类型
克隆号
抗原
偶联物
形式
浓度
规格
纯化类型
保存液
内含物
保存条件
运输条件
产品详细信息
Immunogen sequence: MEELEQGLL MQPWAWLQLA ENSLLAKVFI TKQGYALLVS DLQQVWHEQV DTSVVSQRAK ELNKRLTAPP AAFLCHLDNL LRPLLKDAAH PSEATFSCDC VADALILRVR SELSGLPFYW NFHCMLASPS LVSQHLIRPL MGMSLALQCQ VRELATLLHM KDLEIQDYQE SGATLIRDRL KTEPFEENSF LEQFMIEKLP EACSIGDGKP FVMNLQDLYM AVTTQEVQVG QKHQGAGDPH TSNSASLQGI DSQCVNQPEQ LVSSAPTLSA PEKESTGTSG PLQRPQLSKV KRKKPRGLFS (1-299 aa encoded by BC030986)
靶标信息
Double-strand breaks in DNA result from genotoxic stresses and are among the most damaging of DNA lesions. This gene encodes a DNA repair factor essential for the nonhomologous end-joining pathway, which preferentially mediates repair of double-stranded breaks. Mutations in this gene cause different kinds of severe combined immunodeficiency disorders.
仅用于科研。不用于诊断过程。未经明确授权不得转售。
篇参考文献 (0)
生物信息学
蛋白别名: FLJ12610; Non-homologous end-joining factor 1; nonhomologous end-joining factor 1; Protein cernunnos; unnamed protein product; XRCC4-like factor
基因别名: IMD124; MCOPCB13; NHEJ1; XLF
UniProt ID: (Human) Q9H9Q4
Entrez Gene ID: (Human) 79840